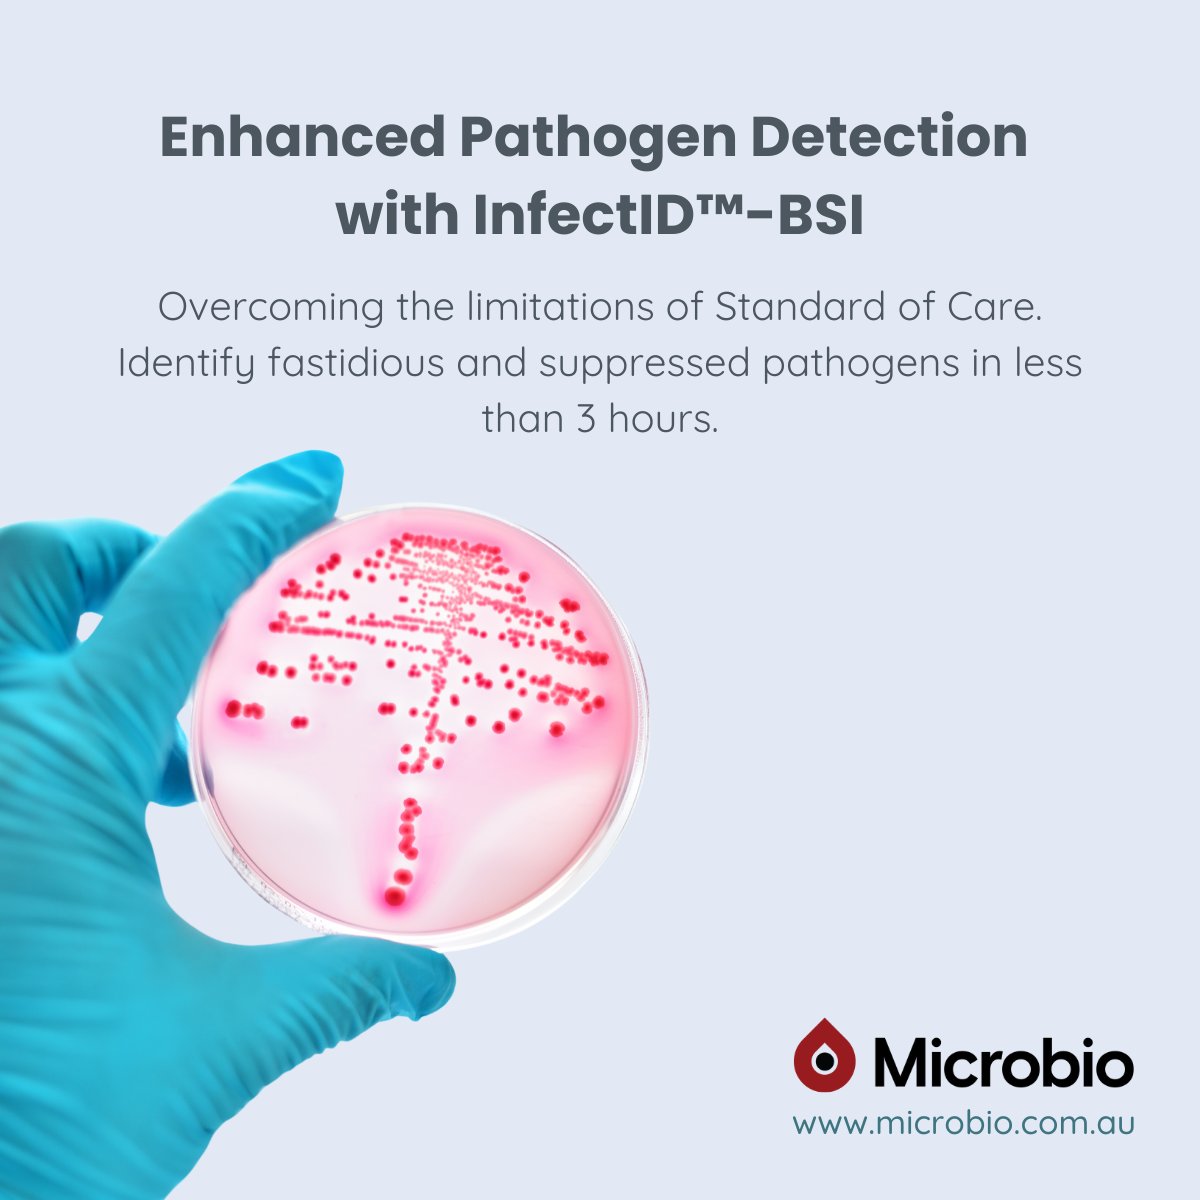
Microbio tweet media

We are delighted to welcome Ana Illera López to Microbio as our new Field Application Specialist!
#WelcomeToTheTeam #Microbio #FieldApplicationSpecialist #Diagnostics #NGS #qPCR #Sepsis #LifeSciences #HealthcareInnovation #TeamGrowth

English
Microbio
593 posts


@MicrobioAus
Leading the paradigm shift in pathogen identification